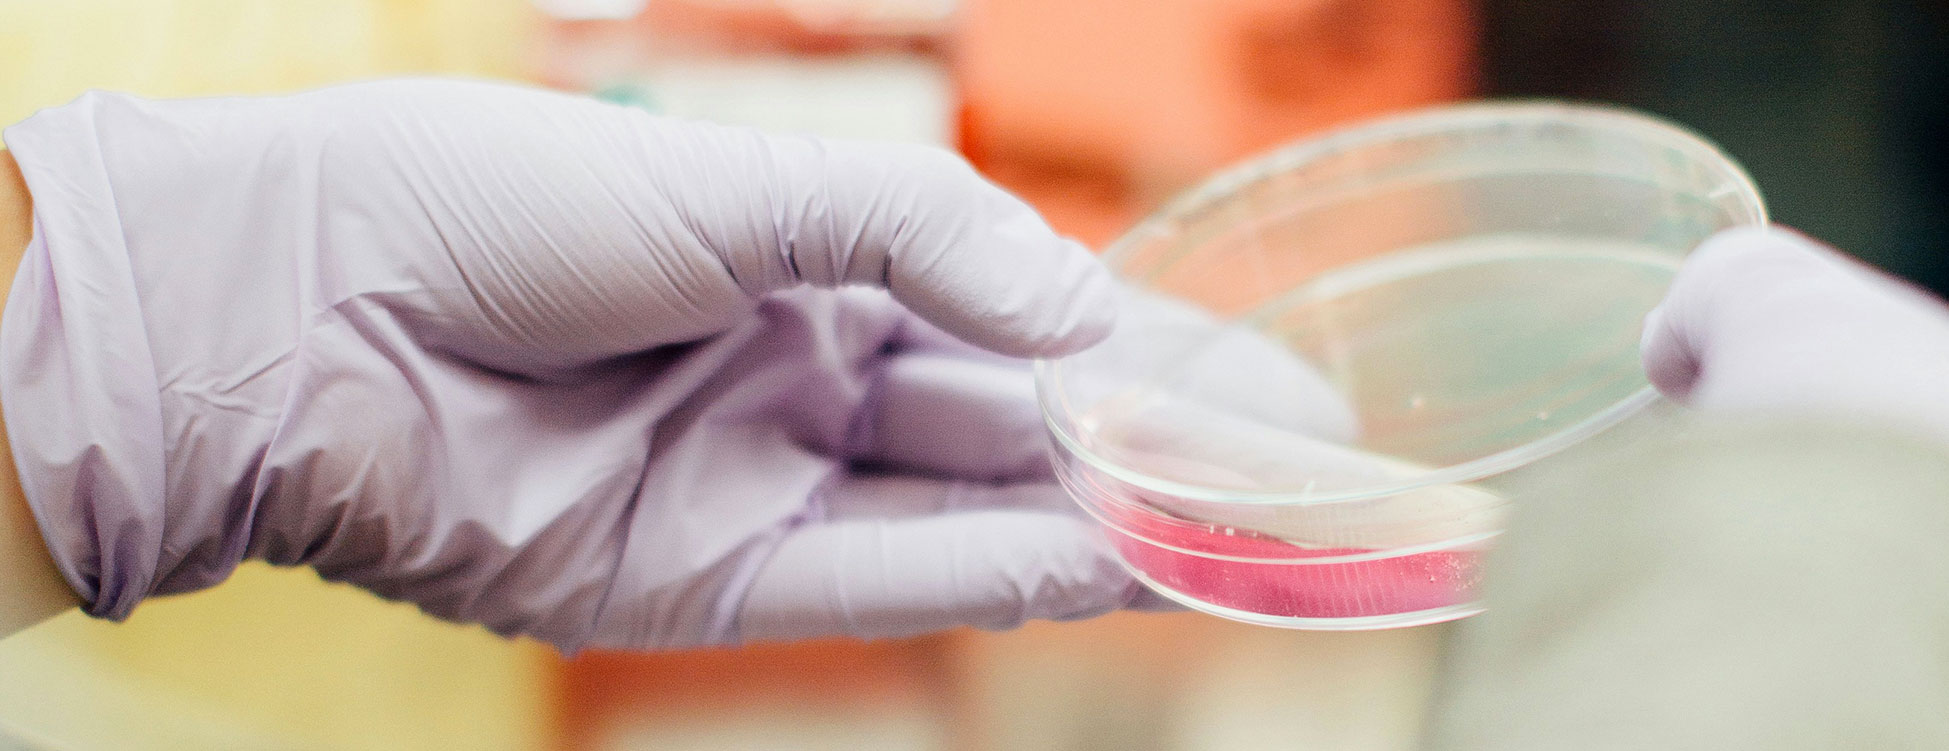

[ DEUTSCH ]

DBG 2025
#HealthySoilsClimateProtection
13 – 18 September 2025
University of Tübingen
Programme booklet (pdf)
Keynote
 Prof. Dr. Johannes Lehmann (Cornell University, USA)
Prof. Dr. Johannes Lehmann (Cornell University, USA)
Soil in Climate Change MitigationThe apparent enigma of how plant litter is transformed into soil organic matter, and why it persists in soil remains a point of vibrant exploration. Building on the soil continuum model, microbial death pathways, and new modeling data I intend to argue that necromass is not the main microbial carbon input to soil. Microorganisms on the one hand mineralize plant litter and organic amendments to carbon dioxide and thereby decrease SOC, while transformation of crop residues to microbial products also increases organic carbon persistence and thereby increases SOC. This apparent contradiction may be explained by greater reactivity and thereby greater interactions between mineral matter and microbial products than unaltered plant residues in soil as shown after calcium additions. Soil organic matter accrual has to be understood as a multi-step process of microbial use that decreases its availability not by producing materials that can in itself not be utilized but by producing materials that become more persistent through mineral interactions. An intriguing area of inquiry remains the question whether molecular diversity is enhanced by decomposition and in a negative feedback reduced mineralization. The balance between mineralization and retention of organic carbon in soil questions the concept of ‘sequestration’ as part of climate change mitigation as locking away carbon for the long term, but rather suggests the need for constant care and soil stewardship. The concurrent advocacy for ‘carbon for soil’ in lieu of ‘soil for carbon’ also reflects the limitations of the soil to store more organic carbon.
Programme
Programme booklet for download
CONTACT
F&U confirm
Permoserstr. 15
04318 Leipzig | Germany
Phone: +49 (0)341 6025 1827

